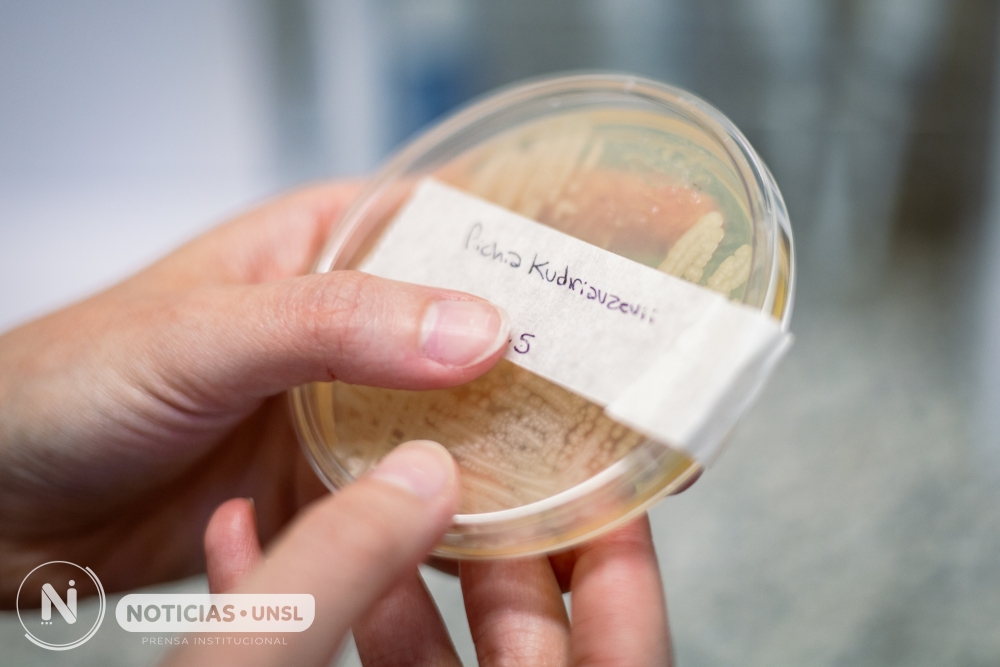

El cuidado del medioambiente y la remediación del recurso hídrico sigue siendo foco de estudios y análisis de grupos científicos a nivel mundial. En San Luis, investigadores del Instituto de Investigaciones en Tecnología Química (INTEQUI) de doble dependencia UNSL/CONICET, buscan nuevas alternativas a partir de la química bioorgánica, la biotecnología y la biología molecular para el tratamiento de grandes cuerpos de aguas contaminados por desechos de las industrias textiles.
La licenciada en Biología Molecular y actual estudiante del doctorado en Biología, Agustina Arce Becerra, está al frente de un trabajo que tiene como objetivo el aislamiento y selección de hongos filamentosos y levaduras para la remoción de colorantes textiles. Se trata de una alternativa para poder utilizar hongos filamentosos, plantas, proteínas o enzimas derivados de esos organismos para metabolizar o degradar contaminantes.
Específicamente, Agustina se centra en la micorremediación, entendida como la biorremediación con hongos, y en su línea de investigación trabaja con hongos filamentosos y levaduras aisladas de lagunas facultativas de efluentes textiles. Estas lagunas son el sitio donde se depositan los efluentes de las industrias textiles, es decir donde se acumulan los desechos que vienen de la industria.

La científica explicó que la hipótesis de su trabajo consiste en que la comunidad microbiana que está presente en esos sitios contaminados, tienen capacidad para poder tolerar y metabolizar estos contaminantes. En este sentido, la hipótesis se centra en que esa comunidad microbiana asimila y se adapta a estar expuesta a estos contaminantes.
Agustina remarcó que su trabajo requiere de diferentes etapas. La primera fase, que ya está cumplida, se enfocó en el aislamiento de microorganismos provenientes de estas lagunas para evaluar su capacidad de remoción de contaminantes, en este caso, colorantes. «Tomamos muestras del agua residual y también de los sedimentos. Del sedimento fue de donde pudimos aislar los hongos con una estrategia de presión de selección y los enfrentamos a concentraciones crecientes de colorantes con las aguas residuales de donde provienen», explicó.
La investigadora sostuvo que se obtuvieron cuatro (4) colonias diferentes morfológicamente a las que se las identificó molecularmente para saber qué especies eran. «A los microorganismos los aislé, identifiqué y seleccioné según su tolerancia y capacidad de remoción y me he quedado con uno de ellos, que es una levadura de la especie Pichia kudriavzevii y es con ésta que estoy haciendo ensayos y optimizando el medio de cultivo para ver cuáles son las mejores condiciones en las que esta levadura metaboliza o decolora los colorantes», sintetizó y remarcó que lo que buscan con estas técnicas es evaluar si estos microorganismos tienen capacidades para degradarlos o utilizarlos incluso como nutrientes en algunos casos.
«Para nuestro estudio nos quedamos con Pichia kudriavzevii porque fue la que presentó mayor tolerancia a dos (2) colorantes presentes en los procesos industriales textiles que son el Rojo Congo y el Amarillo de Alizarina R (…) evaluamos que presentó mejores resultados de decoloración y que crecía un poco mejor en estas condiciones extremas», contó Agustina.
A partir de ahora, otra etapa del trabajo consiste en poder optimizar esos medios para aumentar su capacidad de decoloración y después estudiarlo a nivel proteómico, es decir evaluar qué proteínas se expresan en presencia y en ausencia del colorante para estudiar los mecanismos moleculares puestos en juego. «Recién ahora con los análisis que hagamos de proteómica podremos ver qué proteínas se expresaron en esas condiciones, entonces ahí vamos a poder ver si hay respuesta al estrés, si hay enzimas que se expresan específicamente para degradar estos contaminantes, y poder ver a escala molecular cuáles son los mecanismos moleculares que se ponen en juego en esas condiciones», contó.
Aporte social. La joven científica sostuvo que primeramente este tipo de estudios contribuyen al bienestar del medioambiente, en el uso y cuidado del agua. La industria textil en general, usa mucha agua, lo que representa un gran caudal que no se puede reutilizar por las características y los contaminantes que presenta, entonces el poder usar microorganismos que son parte del mismo ambiente otorgan nuevas alternativas.

«Quizás el agua no vuelva a ser potable, pero sí podrá reutilizarse por ejemplo, para riego de cultivos. Es muy riesgoso que el efluente entre en contacto con las napas, ya que resulta perjudicial para los ecosistemas acuáticos, el suelo y los procesos fotosintéticos, debido a que los colorantes impiden el ingreso de luz al agua. Además, muchos de estos compuestos son potencialmente cancerígenos. Todos estos riesgos impulsan la búsqueda de alternativas de remediación, entre las cuales la biorremediación se presenta como una opción viable para incorporarla al tratamiento de efluentes textiles», expuso.
Datos
Este estudio titulado: Aislamiento y selección de hongos filamentosos y levaduras para la remoción de colorantes textiles, fue seleccionado por la UNSL para representar a la Institución en un evento internacional de jóvenes investigadores organizado por la Asociación de Universidades Grupo Montevideo (AUGM), una red de universidades públicas, autónomas y autogobernadas de Argentina, Bolivia, Brasil, Chile, Paraguay y Uruguay.
En paralelo, esta investigación forma parte del proyecto científico: Levaduras autóctonas para biorremediación: análisis de remoción de colorantes y mecanismos homeostáticos, dirigido por el Dr. José Bonilla que se desarrolla en el INTEQUI. «Los procesos científicos y del conocimiento llevan mucho tiempo y son diversas las miradas científicas que tienen que interactuar para encontrar un resultado», finalizó Agustina.
Nota relacionada
Avanzan en nuevas estrategias para bioremediar el colorante que expulsan las industrias textiles